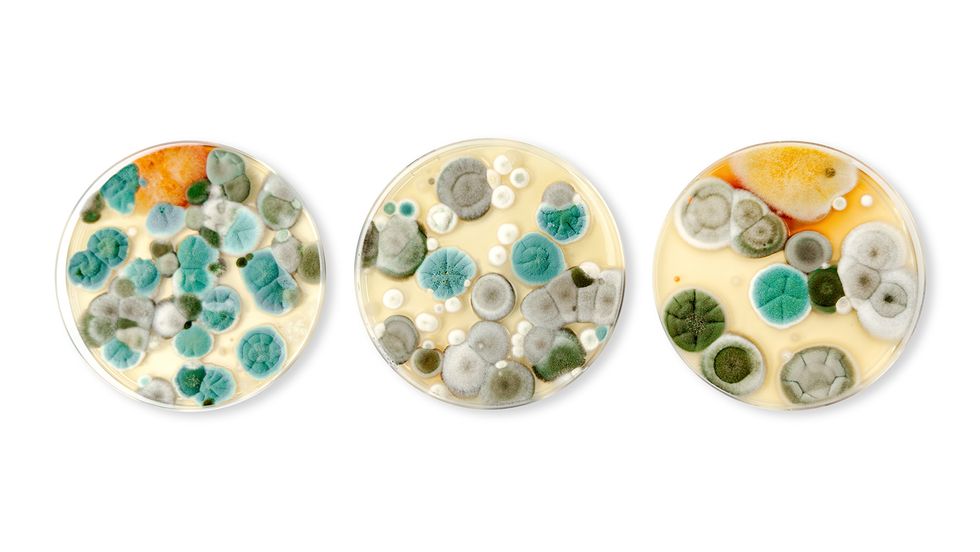
12 Types of Mold That'll Make You Want to Deep-Clean Your House ASAP

In the News
The Copperhead Snake Is Seldom Lethal But Always Venomous
April 13 By Zach Taras, John Perritano
Rube Goldberg: The Man Behind the Ingenious Contraptions
April 10 By Stell Simonton
Oedipus Complex: Digging Into Freud's Controversial Theory
April 10 By John Donovan
Neuschwanstein Castle: The Real Story Behind the Fairy-tale Fortress
April 10 By Dave Roos
The Ring of Fire Is the Pacific's Volcanic Hotspot
April 10 By Mark Mancini
What Is Zionism and Is It Fueling the Palestinian-Israeli Conflict?
April 9 By Dave Roos
Science

The 4th Dimension: Where Science and Imagination Collide

Golden Gate Bridge Facts for Your Next Trivia Night

Desalination Plants: The Future of a Sustainable Water Supply

What Is the Rainiest City in the U.S.? Here are the Top 11
Culture

Why Are Wishbones Supposed to be Lucky?

The World's Oldest Tattoo Shop Has Been in Business Since 1300

Gen Z Age Range, Traits and Nicknames

Top 12 Countries the U.S. Owes Money To